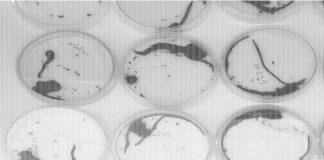
Provedba važnog projekta “DEFENSoil” na Odjelu za

Iz medija - 2016.
Uspješno održana 20. Smotra Sveučilišta Josipa Jurja Strossmayera u Osijeku
SVEUČILIŠNI GLASNIK BROJ 14.
20-8Preuzmi
Projekt “Biofortifikacija selenom – odgovor sustava biljka-tlo-gujavice
SVEUČILIŠNI GLASNIK BROJ 14.
20-2Preuzmi
Realiziran niz projekata u suradnji s gospodarstvom i jedinicama lokalne samouprave
SVEUČILIŠNI GLASNIK BROJ 14.
18-10Preuzmi
Ukupno 2252 mjesta za upis na sveučilišne diplomske studije
SVEUČILIŠNI GLASNIK BROJ 14.
16-02Preuzmi